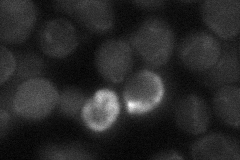
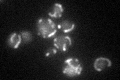

View description
Larger subunit of the mitochondrial processing protease (MPP), essential processing enzyme that cleaves the N-terminal targeting sequences from mitochondrially imported proteins
Localization:
Intensity:
Fold change:
Significance:
-
C’ GFP library in SD

mitochondria61.44 -
N' NOP1pr-GFP in SD

mitochondria71.9546 -
N' TEF2pr-mCherry in SD

mitochondriaN/A -
N' NATIVEpr-GFP in SD
below threshold21.0345 -
N' TEF2pr-VC and Cyto-VN in SD

#N/A0 -
C’ GFP library in SD+DTT

mitochondria75.911.23No -
C’ GFP library in SD+H2O2

mitochondria61.641No -
C’ GFP library in Starvation Media
mitochondria46.650.75No -
C’ GFP library on the background of Pup2-DaMP

mitochondria -
C’ GFP library on the background of CCT mutant

mitochondria74.69131.21544No
